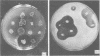
1857

Abstract
Auxotrophic strains of Micromonospora rosaria were isolated by N-methyl-N'-nitro-N'-nitrosoguanidine mutagenesis and used in intraspecific recombination by protoplast fusion. High-frequency fusion of protoplasts of M. rosaria strains was induced by polyethylene glycol (molecular weight, 1,000) (PEG 1,000). The optimum concentration of PEG 1,000 for fusion of M. rosaria was 50% (wt/vol). PEG 4,000 was slightly better than PEG 1,000 at concentrations lower than 50% (wt/vol). The recombinant frequency did not increase after treatment with PEG 1,000 (50% [wt/vol]) for longer than 20 min. Under these conditions, fusion with many auxotrophic strains of M. rosaria resulted in a high frequency of formation of true recombinants (sometimes more than 10%). Additionally, when ros (rosamicin nonproducing) strains were crossed by protoplast fusion; about 5% of the resultant prototrophic recombinants were shown to have the ros+ (rosamicin producing) characteristic restored. Rosamicin production by M. rosaria colonies was clearly distinguished by the broth overlay method. The results of fusion experiments between ros and ros+ strains indicated that either the chromosomal mutation or pleiotrophic effect of some auxotrophic markers is involved.
Full text
PDF




Images in this article
Selected References
These references are in PubMed. This may not be the complete list of references from this article.
- Alföldi L. Fusion of microbial protoplasts: problems and perspectives. Basic Life Sci. 1982;19:59–71. doi: 10.1007/978-1-4684-4142-0_7. [DOI] [PubMed] [Google Scholar]
- Delić V., Hopwood D. A., Friend E. J. Mutangenesis by N-methyl-N'-nitro-N-nitrosoguanidine (NTG) in Streptomyces coelicolor. Mutat Res. 1970 Feb;9(2):167–182. doi: 10.1016/0027-5107(70)90055-2. [DOI] [PubMed] [Google Scholar]
- Hopwood D. A. Genetic studies with bacterial protoplasts. Annu Rev Microbiol. 1981;35:237–272. doi: 10.1146/annurev.mi.35.100181.001321. [DOI] [PubMed] [Google Scholar]
- Hopwood D. A., Wright H. M., Bibb M. J., Cohen S. N. Genetic recombination through protoplast fusion in Streptomyces. Nature. 1977 Jul 14;268(5616):171–174. doi: 10.1038/268171a0. [DOI] [PubMed] [Google Scholar]
- Hopwood D. A., Wright H. M. Factors affecting recombinant frequency in protoplast fusions of Streptomyces coelicolor. J Gen Microbiol. 1979 Mar;111(1):137–143. doi: 10.1099/00221287-111-1-137. [DOI] [PubMed] [Google Scholar]
- Luedemann G. Micromonospora taxonomy. Adv Appl Microbiol. 1969;11:101–133. doi: 10.1016/s0065-2164(08)70608-7. [DOI] [PubMed] [Google Scholar]
- Ochi K., Hitchcock M. J., Katz E. High-frequency fusion of Streptomyces parvulus or Streptomyces antibioticus protoplasts induced by polyethylene glycol. J Bacteriol. 1979 Sep;139(3):984–992. doi: 10.1128/jb.139.3.984-992.1979. [DOI] [PMC free article] [PubMed] [Google Scholar]
- Okanishi M., Suzuki K., Umezawa H. Formation and reversion of Streptomycete protoplasts: cultural condition and morphological study. J Gen Microbiol. 1974 Feb;80(2):389–400. doi: 10.1099/00221287-80-2-389. [DOI] [PubMed] [Google Scholar]
- Polsinelli M., Beretta M. Genetic Recombination in Crosses Between Streptomyces aureofaciens and Streptomyces rimosus. J Bacteriol. 1966 Jan;91(1):63–68. doi: 10.1128/jb.91.1.63-68.1966. [DOI] [PMC free article] [PubMed] [Google Scholar]
- Shaw P. D., Piwowarski J. Effects of ethidium bromide and acriflavine on streptomycin production by Streptomyces bikiniensis. J Antibiot (Tokyo) 1977 May;30(5):404–408. doi: 10.7164/antibiotics.30.404. [DOI] [PubMed] [Google Scholar]
- Wagman G. H., Waitz J. A., Marquez J., Murawaski A., Oden E. M., Testa R. T., Weinstein M. J. A new Micromonospora-produced macrolide antibiotic, rosamicin. J Antibiot (Tokyo) 1972 Nov;25(11):641–646. doi: 10.7164/antibiotics.25.641. [DOI] [PubMed] [Google Scholar]
- Wagman G. H., Weinstein M. J. Antibiotic from Micromonospora. Annu Rev Microbiol. 1980;34:537–557. doi: 10.1146/annurev.mi.34.100180.002541. [DOI] [PubMed] [Google Scholar]